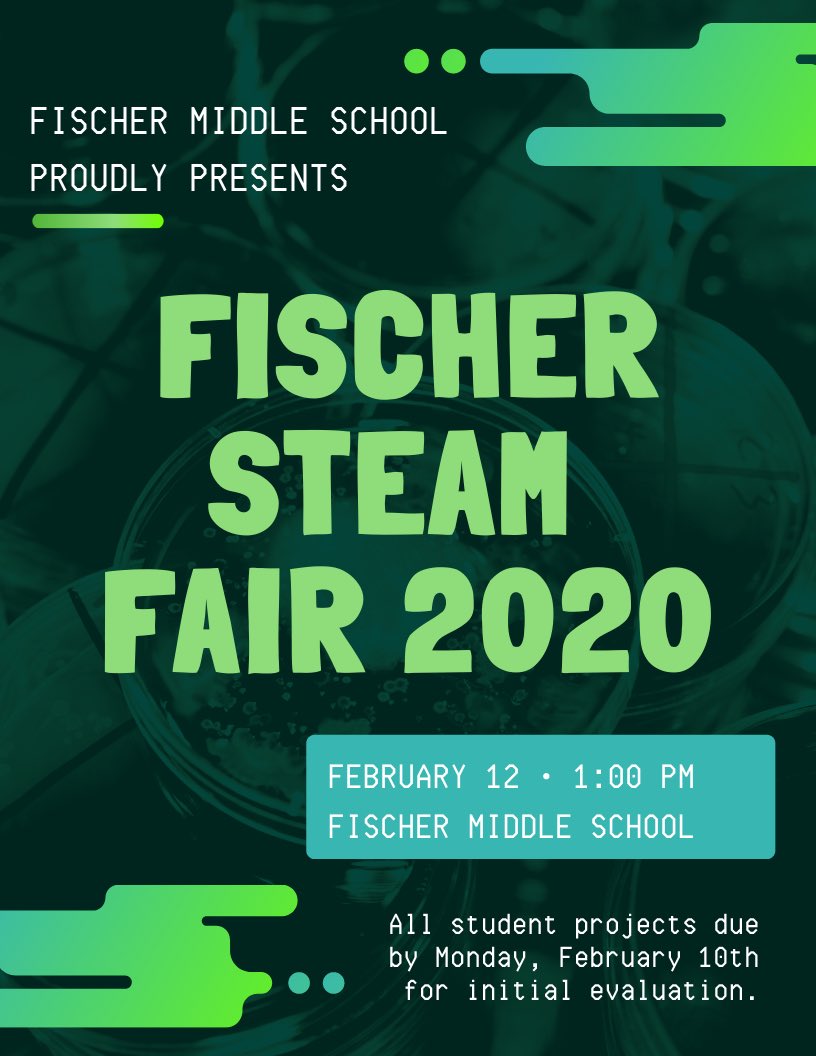
MsGrunewald's tweet image. Getting ready for our #STEAM Fair @FischerSaints @AlumRockUnion #dpvils #fmslearning

#fmslearning kết quả tìm kiếm
Kind of obsessed with this @SlidesManiaSM ‘Mc Krome’ template... using it for my newsletter this week 🤓 #dpvils #alumROCKit #fmslearning

Excited to learn with @drlangraad @iste and so many awesome #educoaches #dpvils #fmslearning #alumROCKit

Our drive-through ‘Fischer Loves Community’ event was a success! What a great way to end the week! @AlumRockUnion #dpvils #fmslearning #arusdunited #arusdunidos




That truly magical moment when a teacher gets their entire class to fill out the survey you need right away✨ So grateful for the awesome educators I get to work with every day #dpvils #fmslearning #alumROCKit
Excited to celebrate @FischerSaints work with the Global Exchange Program during this @SCCOE showcase on Thursday 🌎 #dpvils #alumROCKit #fmslearning #MultilingualAdvocacy

Started the morning off with our virtual Student Awards Assembly 🎉 and now prepping the recording for the livestream later on with @AlumRockUnion #alumROCKit #fmslearning #dpvils

Anyone else in #dpvils working on this with students? 🖍🎨 #fmslearning #alumROCKit
Calling all K-12 US based artists: The time to doodle is approaching! #DoodleForGoogle is back for its 13th year on January 11th, when we’ll announce this year’s theme. Until then, save the date! → goo.gle/2IXRhik
Excited for some excellent sessions today! #dpvils #alumROCKit #fmslearning
Our annual Virtual Conference starts TOMORROW! The 3-day event showcases the innovative ways the #dpvils community has leveraged technology & access to discover, collaborate, and reimagine new ways of teaching & learning. View the sessions in VILS Academy & enroll in your faves!

This session was super helpful! I’m really looking forward to trying out the new co-teacher feature on @PearDeck! #dpvils #fmslearning
Our virtual event with @PearDeck is just minutes away! Join us and learn how to blend Newsela content and Pear Deck strategies. Details here: newse.la/3gBpfWm #appsmashing #newselacommunity
Exciting news! We have an extra week to submit any Doodles y’all! 🎨 #dpvils #alumROCKit #fmslearning
Strength is key in times of uncertainty. To consider those who may be doodling outside of their classrooms or experiencing weather-related challenges, we have extended the #DoodleforGoogle contest deadline to 8:00pm PT on March 5th! Enter here → goo.gle/2MqRkoL
This is a great opportunity to connect and learn together! #dpvils #alumROCKit #fmslearning
Coaches are changemakers. Coaches are cheerleaders. Coaches are listeners. Coaches are leaders. Coaches are relationship-builders. We are so excited to invite you and your network to the Digital Promise #CoachPLC. Join our Coach PLC here: bit.ly/38A9Djq
Excited for @FischerSaints to share our story with @School2Home! @AlumRockUnion #dpvils #fmslearning #alumROCKit
Tomorrow! Join us for our first School2Home leadership Academy! There's still time to register: visit: svefoundation.org/school2home #SVEF, #School2Home, #STEMEd

Happy Monday y’all! Let’s all just take it step by step today 🐾 #dpvils #alumROCKit #fmslearning
This is Ace. He attempted stairs today. Did very well but still feels like there’s room for improvement. 13/10 (IG: ace__adventures)
Just registered, and I can’t wait for this event tomorrow! 🌄🌲#dpvils #alumROCKit #fmslearning
Take an insider tour of CA State Parks TOMORROW at 10amPT at our Flipgrid Live Event with @portsprogram! 🌲🌊 📆 Save the date: aka.ms/EarthDayEvent
Anyone else in #dpvils or @AlumRockUnion registering for this? See y’all there! #alumROCKit #fmslearning
Explore Yellowstone like never before at our next Flipgrid Live Event! 🦌 April 28 at 10am PT. 📆 Don’t miss it! Register now: aka.ms/YellowstoneLive
I’m working on setting up a school wide tech support help desk on @Flipgrid and there are so many good examples to look through... any tips before I share it with Ss and Ts? #dpvils #fmslearning #alumROCKit #FlipgridForAll
Excited for @FischerSaints to share our story with @School2Home! @AlumRockUnion #dpvils #fmslearning #alumROCKit
Tomorrow! Join us for our first School2Home leadership Academy! There's still time to register: visit: svefoundation.org/school2home #SVEF, #School2Home, #STEMEd

Anyone else in #dpvils or @AlumRockUnion registering for this? See y’all there! #alumROCKit #fmslearning
Explore Yellowstone like never before at our next Flipgrid Live Event! 🦌 April 28 at 10am PT. 📆 Don’t miss it! Register now: aka.ms/YellowstoneLive
Just registered, and I can’t wait for this event tomorrow! 🌄🌲#dpvils #alumROCKit #fmslearning
Take an insider tour of CA State Parks TOMORROW at 10amPT at our Flipgrid Live Event with @portsprogram! 🌲🌊 📆 Save the date: aka.ms/EarthDayEvent
Excited to celebrate @FischerSaints work with the Global Exchange Program during this @SCCOE showcase on Thursday 🌎 #dpvils #alumROCKit #fmslearning #MultilingualAdvocacy

Excited for some excellent sessions today! #dpvils #alumROCKit #fmslearning
Our annual Virtual Conference starts TOMORROW! The 3-day event showcases the innovative ways the #dpvils community has leveraged technology & access to discover, collaborate, and reimagine new ways of teaching & learning. View the sessions in VILS Academy & enroll in your faves!

Exciting news! We have an extra week to submit any Doodles y’all! 🎨 #dpvils #alumROCKit #fmslearning
Strength is key in times of uncertainty. To consider those who may be doodling outside of their classrooms or experiencing weather-related challenges, we have extended the #DoodleforGoogle contest deadline to 8:00pm PT on March 5th! Enter here → goo.gle/2MqRkoL
That truly magical moment when a teacher gets their entire class to fill out the survey you need right away✨ So grateful for the awesome educators I get to work with every day #dpvils #fmslearning #alumROCKit
Our drive-through ‘Fischer Loves Community’ event was a success! What a great way to end the week! @AlumRockUnion #dpvils #fmslearning #arusdunited #arusdunidos




Excited to learn with @drlangraad @iste and so many awesome #educoaches #dpvils #fmslearning #alumROCKit

Started the morning off with our virtual Student Awards Assembly 🎉 and now prepping the recording for the livestream later on with @AlumRockUnion #alumROCKit #fmslearning #dpvils

Kind of obsessed with this @SlidesManiaSM ‘Mc Krome’ template... using it for my newsletter this week 🤓 #dpvils #alumROCKit #fmslearning

This is a great opportunity to connect and learn together! #dpvils #alumROCKit #fmslearning
Coaches are changemakers. Coaches are cheerleaders. Coaches are listeners. Coaches are leaders. Coaches are relationship-builders. We are so excited to invite you and your network to the Digital Promise #CoachPLC. Join our Coach PLC here: bit.ly/38A9Djq
Anyone else in #dpvils working on this with students? 🖍🎨 #fmslearning #alumROCKit
Calling all K-12 US based artists: The time to doodle is approaching! #DoodleForGoogle is back for its 13th year on January 11th, when we’ll announce this year’s theme. Until then, save the date! → goo.gle/2IXRhik
Happy Monday y’all! Let’s all just take it step by step today 🐾 #dpvils #alumROCKit #fmslearning
This is Ace. He attempted stairs today. Did very well but still feels like there’s room for improvement. 13/10 (IG: ace__adventures)
I’m working on setting up a school wide tech support help desk on @Flipgrid and there are so many good examples to look through... any tips before I share it with Ss and Ts? #dpvils #fmslearning #alumROCKit #FlipgridForAll
This session was super helpful! I’m really looking forward to trying out the new co-teacher feature on @PearDeck! #dpvils #fmslearning
Our virtual event with @PearDeck is just minutes away! Join us and learn how to blend Newsela content and Pear Deck strategies. Details here: newse.la/3gBpfWm #appsmashing #newselacommunity
Feeling energized and connected after starting my Thursday with everyone in #dpvils on the national call... love seeing the amazing work happening across the network! 💛#fmslearning
Attending one of my first @MicrosoftEDU live events on using AI to fight COVID and learning so much! #dpvils #fmslearning

Excited to learn with @drlangraad @iste and so many awesome #educoaches #dpvils #fmslearning #alumROCKit

Attending one of my first @MicrosoftEDU live events on using AI to fight COVID and learning so much! #dpvils #fmslearning

Exploring how AI can help our oceans as part of our #HourofCode2019 week @FischerSaints @maimonaberta @AlumRockUnion #fmslearning #dpvils #alumROCKit

So proud of our @FischerSaints Students of the Month! @AlumRockUnion #fmslearning #alumROCKit #dpvils



@FischerSaints getting set up for the @AlumRockUnion #STEAM Showcase at @RAFTBayArea and the prosthetic arm is already popular! #dpvils #fmslearning

Getting started with our knows and need to knows for our new #humanities #PBL today with @MrsMadril #fmslearning #dpvils




Kind of obsessed with this @SlidesManiaSM ‘Mc Krome’ template... using it for my newsletter this week 🤓 #dpvils #alumROCKit #fmslearning

Our drive-through ‘Fischer Loves Community’ event was a success! What a great way to end the week! @AlumRockUnion #dpvils #fmslearning #arusdunited #arusdunidos




Excited to celebrate @FischerSaints work with the Global Exchange Program during this @SCCOE showcase on Thursday 🌎 #dpvils #alumROCKit #fmslearning #MultilingualAdvocacy

Appreciate the little shout out from @Screencastify 💛 Definitely my go to for creating tutorials for Ts and Ss #TopScreencaster #fmslearning #dpvils #alumROCKit

Grateful for the work @maimonaberta has done to organize our second interfaith panel with @ING_org for our 7th grade #humanities #PBL murals for peace #fmslearning @AlumRockUnion #alumROCKit #dpvils


Using a @CommonSenseEd lesson in @nearpod today with our #TechTeam to have conversations around mental health, finding balance, and addictive design in tech #fmslearning #dpvils @FischerSaints @AlumRockUnion

Started the morning off with our virtual Student Awards Assembly 🎉 and now prepping the recording for the livestream later on with @AlumRockUnion #alumROCKit #fmslearning #dpvils

That truly magical moment when a teacher gets their entire class to fill out the survey you need right away✨ So grateful for the awesome educators I get to work with every day #dpvils #fmslearning #alumROCKit
Fully and shamelessly embracing all the 🍂🍁🍂🍁 in my newsletter today with slidesgo.com #dpvils #fmslearning #alumROCKit

Something went wrong.
Something went wrong.
United States Trends
- 1. Black Friday 423K posts
- 2. Nebraska 7,473 posts
- 3. Egg Bowl 6,553 posts
- 4. Black Ops 7 Blueprint 4,451 posts
- 5. Sumrall 2,147 posts
- 6. Mississippi State 3,880 posts
- 7. Black Ops 7 XP 4,571 posts
- 8. #Huskers N/A
- 9. Emmett Johnson N/A
- 10. #Illini N/A
- 11. Scott Stricklin 1,167 posts
- 12. #releafcannabis N/A
- 13. #HMxCODSweepstakes N/A
- 14. NextNRG Inc 1,812 posts
- 15. Chambliss 1,470 posts
- 16. Kamario Taylor N/A
- 17. Fisch 1,367 posts
- 18. #SkylineSweeps 1,013 posts
- 19. Napier 1,234 posts
- 20. Carson Soucy N/A